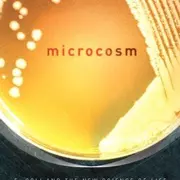
Rachel Kushner

Rachel Kushner's most popular book is Creation Lake with 217 saves and an average rating of 3.48.
Series
1 primary bookAuthored 0% of series
La Grande Rivolta is a 1-book series first released in 1971 with contributions by Nanni Balestrini.
Series
14 primary booksAuthored 0% of series
The Best American Nonrequired Reading is a 14-book series with 14 released primary works first released in 2002 with contributions by Dave Eggers and 826 National.